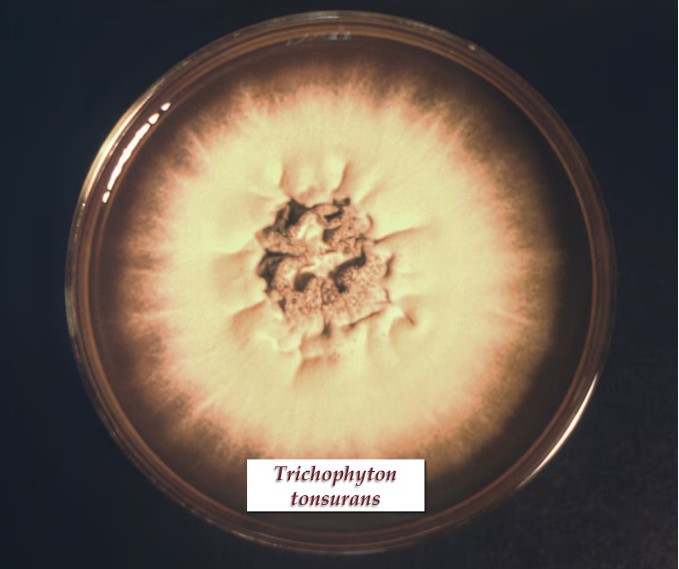

Mundial 2026: qué dice la ciencia sobre los penales, las cábalas y la presión.
El Gobernador compartió con vecinos de barrio 20 de Febrero la jornada “La Muni en tu barrio”
El gobernador Gustavo Sáenz compartió en barrio 20 de Febrero una jornada de la La Muni en tu Barrio.
Junto al Intendente de Salta, el mandatario recorrió los diversos puestos de servicios que brinda la Municipalidad y acompaña el Gobierno de la Provincia.
El gobernador Gustavo Sáenz y el intendente de Salta Emiliano Durand estuvieron en el centro vecinal de barrio 20 de Febrero. Allí se realizó el programa “La Muni en tu barrio” con el objetivo de descentralizar de los servicios de la comuna con la participación de la Provincia.
Tras recorrer cada uno de los stands de atención y dialogar con el personal, profesionales y vecinos, el Gobernador destacó la importancia de estar presentes en los barrios de la Ciudad, escuchando a los vecinos y acercando los servicios que la Provincia y Municipalidad brindan en un trabajo articulado.
“Siempre cerca y al lado de la gente, con los equipos de la Provincia y la Municipalidad en conjunto para dar la oportunidad a quienes no pueden hacer sus trámites los días de semana, los hagan los sábados”, expresó el Gobernador.
En tanto el intendente afirmó que esta modalidad se mantendrá, llegando a todos los vecinos capitalinos.
Los puestos de atención atendieron consultas de los vecinos sobre los servicios municipales como habilitaciones, alumbrado público, microbasurales, desmalezado, camión atmosférico, inspecciones, señalización, planos, licencias de conducir, armado de notas y currículum vitae con simulación de entrevistas, de vacunación antirrábica, atención en peluquería, testeos rápidos de VIH, móvil odontológico, entre otros.
En tanto, la Provincia se hizo presente con el Ente de los Servicios Públicos, Aguas del Norte y los servicios que brinda el Ministerio de Salud con el camión oncológico, mamografia y de ginecología.


 CRONOS HD
CRONOS HD

Comentarios
¡Sin comentarios aún!
Se el primero en comentar este artículo.
Deja tu comentario